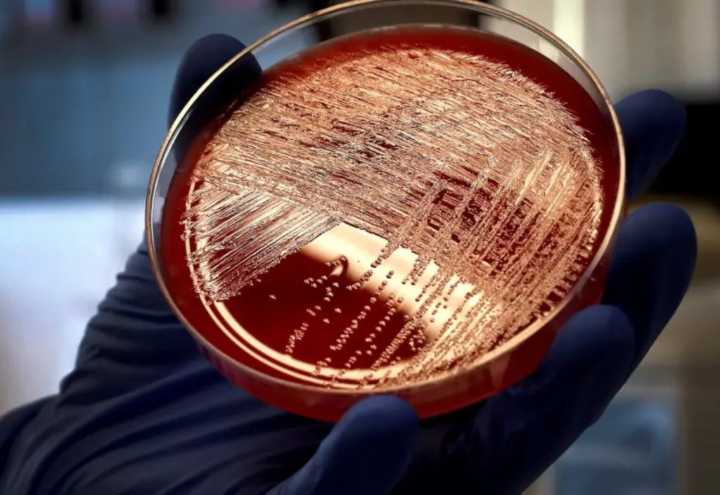
Brote de listeria en EE.UU. deja seis muertos

Al menos seis personas han muerto en Estados Unidos a causa de un brote de la bacteria Listeria monocytogenes vinculado con ensaladas y pastas preparadas vendidas en supermercados como Walmart, Kroger y Trader Joe’s, alertaron los Centros para el Control y la Prevención de Enfermedades (CDC).
Desde el 1 de agosto hasta el 16 de octubre, se han confirmado 27 casos en 18 estados, incluyendo siete nuevos contagios recientes y dos fallecimientos en Hawái y Oregón. Los CDC advirtieron que el número real de afectados podría ser mayor, ya que no todos los pacientes se someten a pruebas de laboratorio.
El organismo señaló que los alimentos contaminados provienen de la sección refrigerada y que las personas enfermas reportaron haber consumido platillos con pasta, especialmente pollo y fetuchini c

El Heraldo San Luis Potosí
Diario Marca Oaxaca DEPORTE
La Opinión México
Associated Press Spanish
OKDIARIO Estados Unidos
@MSNBC Video
Raw Story
Associated Press US and World News Video
Political Wire
Providence Journal Sports
Just Jared
Cache Valley Daily